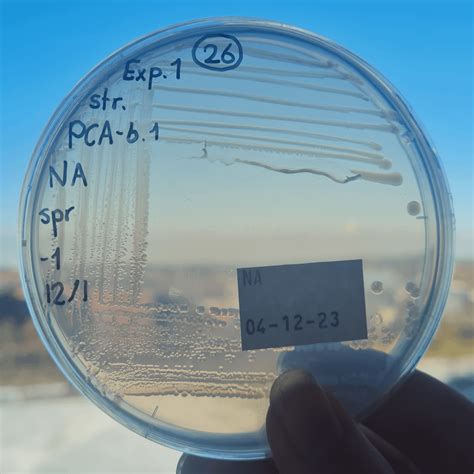

Pseudomonas Spp: Microbiology Unveiled
Pseudomonas spp: Microbiology Unveiled
Hey guys! Ever wondered about those tiny critters that play a huge role in our world? Let’s dive into the world of Pseudomonas spp. , a group of bacteria that’s way more interesting than you might think. In this article, we’re breaking down everything you need to know about these fascinating microorganisms, from their basic biology to their impact on various fields like medicine, agriculture, and even environmental science. So, buckle up and get ready for a microbiological adventure!
Table of Contents
What Exactly is Pseudomonas spp.?
When we talk about Pseudomonas spp. , we’re referring to a genus of bacteria. Think of it like a big family, with lots of different members (species) that share some common traits. Pseudomonas bacteria are Gram-negative, which basically means their cell walls have a particular structure that stains pink in a Gram stain test. They’re rod-shaped, meaning they look like little sticks under a microscope, and they’re usually motile, thanks to their polar flagella – tiny, whip-like structures that help them swim around. What really sets Pseudomonas apart is their versatility. They’re found everywhere – in soil, water, and even on plants and animals. They’re also incredibly adaptable, able to survive in a wide range of environments and use a variety of different compounds as food. This adaptability is one of the reasons why Pseudomonas are so important (and sometimes problematic) in different fields. For example, their ability to break down pollutants makes them useful in bioremediation, while their ability to cause infections makes them a concern in healthcare. So, when you hear the term Pseudomonas spp. , think of a diverse and adaptable group of bacteria that’s always up to something.
The Key Characteristics of Pseudomonas
Understanding the key characteristics of Pseudomonas is essential for appreciating its significance in various fields. Pseudomonas exhibits a range of traits that contribute to its ecological success and clinical relevance. First off, their metabolic versatility is truly remarkable. These bacteria can utilize a wide array of organic compounds as carbon and energy sources, allowing them to thrive in diverse environments. This metabolic flexibility also makes them valuable in bioremediation, where they can break down pollutants and clean up contaminated sites. Another important characteristic is their ability to form biofilms. Biofilms are communities of bacteria encased in a self-produced matrix, which provides protection against antibiotics and disinfectants. This makes Pseudomonas infections particularly challenging to treat, as the biofilm shields the bacteria from the effects of antimicrobial agents. Furthermore, Pseudomonas produces a variety of virulence factors that contribute to its pathogenicity. These include toxins, enzymes, and pigments that can damage host tissues and evade the immune system. For example, Pseudomonas aeruginosa produces exotoxin A, which inhibits protein synthesis in host cells, leading to tissue damage and inflammation. The production of siderophores, molecules that scavenge iron, is another key characteristic. Iron is essential for bacterial growth, and siderophores allow Pseudomonas to acquire iron from the environment, even in iron-limited conditions. Finally, the intrinsic antibiotic resistance of Pseudomonas is a major concern in healthcare. These bacteria possess several mechanisms to resist the effects of antibiotics, including the production of enzymes that degrade antibiotics, the expression of efflux pumps that pump antibiotics out of the cell, and mutations in target genes that reduce antibiotic binding. In summary, the key characteristics of Pseudomonas – metabolic versatility, biofilm formation, virulence factors, siderophore production, and antibiotic resistance – make it a formidable microorganism with significant implications for human health and the environment.
Common Species Within the Pseudomonas Genus
The Pseudomonas genus is vast, with numerous species each possessing unique traits and ecological roles. Let’s explore some of the most common and well-studied species. Pseudomonas aeruginosa is probably the most famous, or rather, infamous member of the family. It’s an opportunistic pathogen, meaning it usually infects people with weakened immune systems. It’s a major cause of hospital-acquired infections, particularly pneumonia, bloodstream infections, and wound infections. P. aeruginosa is notorious for its antibiotic resistance, making it a tough bug to beat. Then there’s Pseudomonas fluorescens , a more benign species often found in soil and water. It’s a plant growth-promoting bacterium, meaning it helps plants grow by producing beneficial compounds and protecting them from diseases. P. fluorescens is also used in bioremediation to clean up contaminated soil and water. Another notable species is Pseudomonas putida , which is also found in soil and water. It’s known for its ability to degrade a wide range of organic compounds, including pollutants like toluene and xylene. P. putida is used in bioreactors to treat industrial wastewater and in the production of certain chemicals. Pseudomonas syringae is a plant pathogen that causes a variety of diseases in crops and ornamental plants. It produces ice nucleation proteins, which promote the formation of ice crystals on plant surfaces, leading to frost damage. Finally, there’s Pseudomonas stutzeri , a versatile species found in diverse environments, including soil, water, and even the human body. It’s known for its ability to denitrify, meaning it can convert nitrate to nitrogen gas, which is important in the nitrogen cycle. These are just a few examples of the many species within the Pseudomonas genus. Each species has its own unique characteristics and ecological role, highlighting the diversity and adaptability of this important group of bacteria.
The Role of Pseudomonas in Various Environments
The adaptability of Pseudomonas allows it to thrive in a variety of environments. In soil , Pseudomonas plays a crucial role in nutrient cycling. These bacteria can break down complex organic matter, releasing nutrients like nitrogen and phosphorus that plants can use. Some species, like Pseudomonas fluorescens , even promote plant growth directly by producing hormones and protecting plants from pathogens. In water , Pseudomonas contributes to the breakdown of organic pollutants. Their metabolic versatility allows them to degrade a wide range of compounds, including petroleum hydrocarbons, pesticides, and industrial solvents. This makes them valuable in bioremediation efforts to clean up contaminated water sources. Pseudomonas also plays a role in the atmosphere , believe it or not. Some species can form ice nuclei, which are particles that promote the formation of ice crystals in clouds. This can influence precipitation patterns and weather events. In healthcare settings , Pseudomonas aeruginosa is a major concern. It can cause infections in the lungs, bloodstream, urinary tract, and skin, particularly in patients with weakened immune systems. The ability of P. aeruginosa to form biofilms and resist antibiotics makes these infections difficult to treat. In industrial settings , Pseudomonas can be both beneficial and detrimental. On one hand, their ability to degrade pollutants makes them useful in wastewater treatment and bioremediation. On the other hand, they can cause spoilage of food and other products, leading to economic losses. Finally, in research , Pseudomonas is a valuable model organism for studying bacterial physiology, genetics, and pathogenesis. Their relatively simple genome and rapid growth rate make them easy to work with in the lab. So, whether it’s cycling nutrients in the soil, cleaning up pollutants in the water, or causing infections in hospitals, Pseudomonas is a significant player in many different environments.
Medical Significance: Infections and Treatments
The medical significance of Pseudomonas , particularly Pseudomonas aeruginosa , cannot be overstated. This opportunistic pathogen is a major cause of infections in hospitals, especially among patients with compromised immune systems, such as those with cystic fibrosis, burns, or undergoing chemotherapy. Pseudomonas infections can affect various parts of the body, including the lungs (pneumonia), bloodstream (bacteremia), urinary tract (UTI), skin (wound infections), and even the eyes (keratitis). These infections are often severe and can be life-threatening, particularly in vulnerable populations. One of the biggest challenges in treating Pseudomonas infections is the bacteria’s intrinsic antibiotic resistance. P. aeruginosa possesses several mechanisms to resist the effects of antibiotics, including the production of enzymes that degrade antibiotics, the expression of efflux pumps that pump antibiotics out of the cell, and mutations in target genes that reduce antibiotic binding. This resistance makes it difficult to find effective antibiotics to treat Pseudomonas infections. Treatment options typically involve a combination of antibiotics, often including drugs like aminoglycosides, carbapenems, and fluoroquinolones. However, the choice of antibiotics depends on the specific strain of Pseudomonas and its resistance profile. In some cases, antibiotic susceptibility testing is necessary to determine which antibiotics are most likely to be effective. In addition to antibiotics, other treatment strategies may be necessary, such as surgical debridement of infected tissues, drainage of abscesses, and supportive care to maintain organ function. Prevention is also key to reducing the risk of Pseudomonas infections, especially in healthcare settings. This includes strict adherence to infection control practices, such as hand hygiene, proper wound care, and isolation of infected patients. Research is ongoing to develop new strategies to combat Pseudomonas infections, including new antibiotics, vaccines, and therapies that target the bacteria’s virulence factors. Understanding the medical significance of Pseudomonas and implementing effective prevention and treatment strategies are crucial for improving patient outcomes and reducing the burden of these challenging infections.
Industrial and Biotechnological Applications
Beyond their medical significance, Pseudomonas bacteria have a wide range of industrial and biotechnological applications. Their metabolic versatility and ability to degrade a variety of compounds make them valuable in various processes. In bioremediation , Pseudomonas is used to clean up contaminated soil and water. Species like Pseudomonas putida can degrade pollutants like petroleum hydrocarbons, pesticides, and industrial solvents, converting them into less harmful substances. This makes them useful in treating oil spills, cleaning up contaminated industrial sites, and removing pollutants from wastewater. In agriculture , Pseudomonas fluorescens is used as a biocontrol agent to protect plants from diseases. It produces compounds that inhibit the growth of plant pathogens and stimulates the plant’s immune system. P. fluorescens can also promote plant growth by producing hormones and increasing nutrient availability. In the chemical industry , Pseudomonas is used to produce a variety of chemicals, including enzymes, amino acids, and biopolymers. Their ability to utilize different carbon sources and perform specific chemical reactions makes them valuable in the production of these compounds. Pseudomonas is also used in the food industry for various purposes, such as the production of fermented foods and the degradation of food waste. However, some species can also cause spoilage of food products, so careful control is necessary. In bioplastics production , some Pseudomonas species can accumulate polyhydroxyalkanoates (PHAs), which are biodegradable polymers that can be used to make bioplastics. This offers a sustainable alternative to traditional plastics made from petroleum. Furthermore, Pseudomonas is used in research as a model organism for studying bacterial metabolism, genetics, and physiology. Their relatively simple genome and rapid growth rate make them easy to work with in the lab. Overall, the industrial and biotechnological applications of Pseudomonas are diverse and continue to expand as researchers discover new ways to harness their unique capabilities. From cleaning up pollution to producing valuable chemicals, these bacteria have a lot to offer.
Conclusion
So, there you have it! Pseudomonas spp. are a diverse and fascinating group of bacteria that play significant roles in various environments, from soil and water to healthcare settings and industrial processes. Their adaptability, metabolic versatility, and unique characteristics make them both beneficial and problematic, depending on the context. Whether they’re helping to clean up pollution, causing infections in hospitals, or contributing to the production of valuable chemicals, Pseudomonas bacteria are always up to something. Understanding these microorganisms is crucial for addressing the challenges they pose and harnessing their potential for the benefit of society. Keep exploring, keep learning, and stay curious about the amazing world of microbiology!